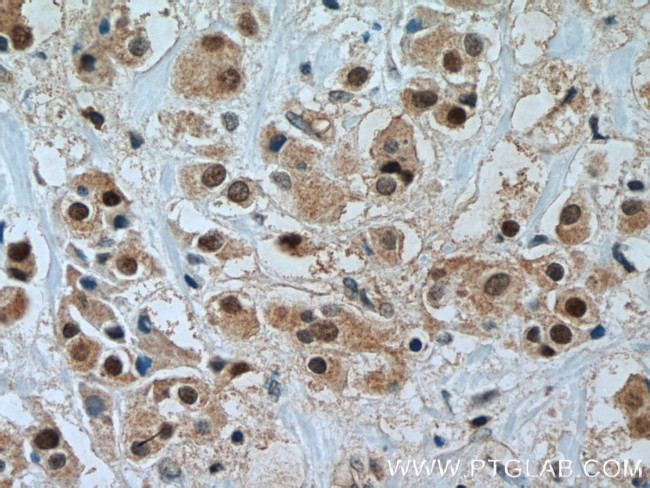
TFAP2C Antibody in Immunohistochemistry (Paraffin) (IHC (P))

Search
Proteintech
TFAP2C Polyclonal Antibody
{{$productOrderCtrl.translations['antibody.pdp.commerceCard.promotion.promotions']}}
{{$productOrderCtrl.translations['antibody.pdp.commerceCard.promotion.viewpromo']}}
{{$productOrderCtrl.translations['antibody.pdp.commerceCard.promotion.promocode']}}: {{promo.promoCode}} {{promo.promoTitle}} {{promo.promoDescription}}. {{$productOrderCtrl.translations['antibody.pdp.commerceCard.promotion.learnmore']}}
产品信息
14572-1-AP
种属反应
已发表种属
宿主/亚型
分类
类型
抗原
偶联物
形式
浓度
规格
纯化类型
保存液
内含物
保存条件
运输条件
产品详细信息
Immunogen sequence: MLWKITDNV KYEEDCEDRH DGSSNGNPRV PHLSSAGQHL YSPAPPLSHT GVAEYQPPPY FPPPYQQLAY SQSADPYSHL GEAYAAAINP LHQPAPTGSQ QQAWPGRQSQ EGAGLPSHHG RPAGLLPHLS GLEAGAVSAR RDAYRRSDLL LPHAHALDAA GLAENLGLHD MPHQMDEVQN VDDQHLLLHD QTVIRKGPIS MTKNPLNLPC QKELVGAVMN PTEVFCSVPG RLSLLSSTSK YKVTVAEVQR RLSPPECLNA SLLGGVLRRA KSKNGGRSLR EKLDKIGLNL PAGRRKAAHV TLLTSLVEGE AVHLARDFAY VCEAEFPSKP VAEYLTRPHL GGRNEMAARK NMLLAAQQLC KEFTELLSQD RTPHGTSRLA PVLETNIQNC LSHFSLITHG FGSQAICAAV SALQNYIKEA LIVIDKSYMN PGDQSPADSN KTLEKMEKHR K (1-450 aa encoded by BC035664)
靶标信息
The protein encoded by this gene is a sequence-specific DNA-binding transcription factor involved in the activation of several developmental genes. The encoded protein can act as either a homodimer or heterodimer with other family members and is induced during retinoic acid-mediated differentiation. It plays a role in the development of the eyes, face, body wall, limbs, and neural tube.
仅用于科研。不用于诊断过程。未经明确授权不得转售。
生物信息学
蛋白别名: Activating enhancer-binding protein 2 gamma; AP-2 gamma; AP2-gamma; estrogen receptor factor 1; Transcription factor AP-2 gamma; Transcription factor ERF-1; unnamed protein product
基因别名: AP2-GAMMA; ERF1; hAP-2g; TFAP2C; TFAP2G
UniProt ID: (Human) Q92754
Entrez Gene ID: (Human) 7022